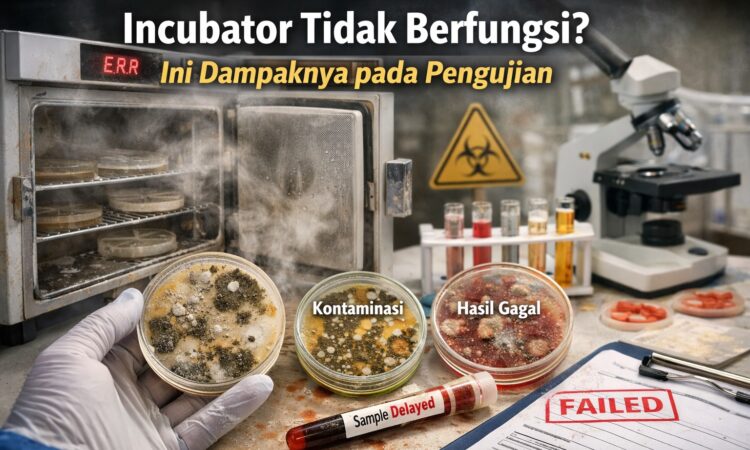

🌡️ Incubator Laboratorium dan Perannya dalam Pengujian
Incubator laboratorium digunakan untuk menjaga kondisi lingkungan tertentu seperti suhu dan kelembaban agar sesuai dengan kebutuhan pengujian, terutama pada analisa mikrobiologi dan pengujian berbasis pertumbuhan.
Namun, masalah yang sering terjadi adalah incubator tidak berfungsi dengan baik, seperti suhu tidak stabil atau tidak sesuai dengan setting.
Masalah ini sering tidak disadari, tetapi dapat berdampak langsung pada validitas hasil pengujian.
👉 Untuk memahami pentingnya kondisi alat secara menyeluruh, baca juga:
Perbaikan Alat Laboratorium: Jangan Tunggu Rusak Total, Ini Risiko dan Solusinya
⚠️ Dampak Incubator Tidak Berfungsi
Jika incubator tidak bekerja optimal, maka risiko yang terjadi antara lain:
1. Pertumbuhan Sampel Tidak Optimal
Suhu yang tidak sesuai dapat menghambat atau merusak pertumbuhan mikroorganisme.
2. Hasil Uji Tidak Valid
Data yang dihasilkan tidak mencerminkan kondisi sebenarnya.
3. Risiko Gagal Audit
Dalam standar ISO/IEC 17025, kondisi alat harus terkontrol dan tervalidasi.
4. Kerugian Operasional
Pengujian harus diulang, menyebabkan pemborosan waktu dan biaya.
🔍 Penyebab Incubator Tidak Berfungsi
Berikut beberapa penyebab yang umum terjadi:
🌡️ 1. Sensor Suhu Bermasalah
Sensor tidak akurat menyebabkan suhu tidak sesuai dengan setting.
⚙️ 2. Controller Error
Kerusakan sistem kontrol menyebabkan incubator tidak stabil.
🔥 3. Heater Tidak Optimal
Elemen pemanas tidak bekerja maksimal.
🔌 4. Gangguan Kelistrikan
Tegangan tidak stabil mempengaruhi performa alat.
🧼 5. Kurangnya Perawatan
Tidak dilakukan maintenance secara berkala.
👉 Baca juga:
5 Tanda Alat Laboratorium Harus Segera Diservice
🛠️ Cara Mengatasi Incubator Tidak Berfungsi
✔ 1. Lakukan Pengecekan Awal
Pastikan alat menyala normal dan tidak ada error.
✔ 2. Verifikasi Suhu
Bandingkan suhu aktual dengan setting.
✔ 3. Periksa Komponen Utama
- sensor suhu
- heater
- controller
✔ 4. Gunakan Teknisi Profesional
Perbaikan incubator membutuhkan keahlian khusus untuk menjaga kestabilan suhu.
💼 Solusi Service Incubator Laboratorium
Jika incubator Anda mengalami:
- suhu tidak stabil
- tidak sesuai setting
- error pada sistem
- tidak berfungsi normal
👉 maka diperlukan service incubator laboratorium oleh teknisi berpengalaman.
Kami menyediakan layanan:
- pengecekan & diagnosa incubator
- perbaikan sensor suhu
- perbaikan heater
- perbaikan controller
- kalibrasi suhu
🔗 Hubungan dengan Alat Lain
Masalah serupa juga sering terjadi pada alat lain:
- oven → tidak panas
- furnace → tidak stabil
- waterbath → tidak presisi
👉 Baca juga:
📞 Konsultasi & Diagnosa Awal GRATIS
Kami telah membantu berbagai laboratorium dalam menangani masalah incubator dan alat lainnya.
Jika Anda mengalami:
- incubator tidak berfungsi
- suhu tidak stabil
- hasil uji tidak konsisten
👉 Anda dapat mengirimkan foto atau video alat untuk diagnosa awal tanpa biaya.
🚀 Jadwalkan Service Sekarang
Incubator yang tidak berfungsi dapat merusak hasil pengujian dan menyebabkan kerugian besar.
👉 Jangan tunggu sampai hasil uji gagal.
Segera lakukan pengecekan dan perbaikan.
Tim Teknis Solusi ISO Produktivitas siap membantu Anda.
📞 WhatsApp: 08112639648
🌐 Website: solusiisoproduktivitas.com
🔚 Kesimpulan
Incubator yang tidak berfungsi merupakan masalah serius yang dapat mempengaruhi validitas hasil pengujian dan efisiensi operasional laboratorium.
Melakukan perbaikan dan maintenance secara berkala adalah langkah penting untuk menjaga kualitas hasil uji.